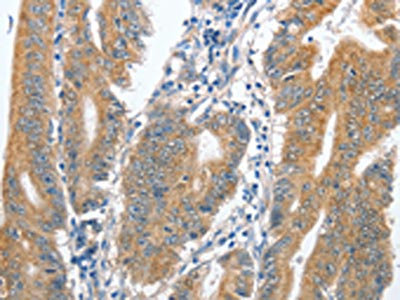

CENPC Antibody
-
中文名稱:CENPC兔多克隆抗體
-
貨號:CSB-PA258870
-
規(guī)格:¥1100
-
圖片:
-
其他:
產(chǎn)品詳情
-
Uniprot No.:
-
基因名:CENPC
-
別名:CENP-C 1 antibody; CENP-C antibody; CENPC_HUMAN antibody; CENPC1 antibody; Centromere autoantigen C antibody; Centromere autoantigen C1 antibody; Centromere protein C 1 antibody; Centromere protein C antibody; hcp-4 antibody; ICEN7 antibody; Interphase centromere complex protein 7 antibody; MIF2 antibody
-
宿主:Rabbit
-
反應種屬:Human
-
免疫原:Fusion protein of Human CENPC
-
免疫原種屬:Homo sapiens (Human)
-
標記方式:Non-conjugated
-
抗體亞型:IgG
-
純化方式:Antigen affinity purification
-
濃度:It differs from different batches. Please contact us to confirm it.
-
保存緩沖液:-20°C, pH7.4 PBS, 0.05% NaN3, 40% Glycerol
-
產(chǎn)品提供形式:Liquid
-
應用范圍:ELISA,IHC
-
推薦稀釋比:
Application Recommended Dilution ELISA 1:2000-1:5000 IHC 1:50-1:200 -
Protocols:
-
儲存條件:Upon receipt, store at -20°C or -80°C. Avoid repeated freeze.
-
貨期:Basically, we can dispatch the products out in 1-3 working days after receiving your orders. Delivery time maybe differs from different purchasing way or location, please kindly consult your local distributors for specific delivery time.
-
用途:For Research Use Only. Not for use in diagnostic or therapeutic procedures.
相關產(chǎn)品
靶點詳情
-
功能:Component of the CENPA-NAC (nucleosome-associated) complex, a complex that plays a central role in assembly of kinetochore proteins, mitotic progression and chromosome segregation. The CENPA-NAC complex recruits the CENPA-CAD (nucleosome distal) complex and may be involved in incorporation of newly synthesized CENPA into centromeres. CENPC recruits DNA methylation and DNMT3B to both centromeric and pericentromeric satellite repeats and regulates the histone code in these regions.
-
基因功能參考文獻:
- Whereas CENP-C recruits a single MIS12:NDC80 complex, the authors show here that CENP-T binds one MIS12:NDC80 and two NDC80 complexes upon phosphorylation by the mitotic CDK1:Cyclin B complex at three distinct CENP-T sites. PMID: 28012276
- CENP-C specifically binds alpha satellite non-coding RNAs. PMID: 28787590
- A nonhistone centromere protein, CENP-C, binds and reshapes the nucleosome, sliding the DNA gyres back to positions similar to those in canonical nucleosomes containing conventional histone H3. PMID: 26878239
- HPV18 E7 inhibited the binding of CENP-C to alpha-satellite DNAs. PMID: 25997930
- CENP-C recruits the Ndc80 complex through its interactions with KNL1 and the Mis12 complex at kinetochores during chromosome segregation. PMID: 25660545
- CENP-C, a CCAN subunit, is crucial for kinetochore assembly because it links centromeres with the microtubule-binding interface of kinetochores. PMID: 26124289
- CENP-C affects nucleosome shape and dynamics in a manner analogous to allosteric regulation of enzymes. CENP-C depletion leads to rapid removal of CENP-A from centromeres, indicating their collaboration in maintaining centromere identity. PMID: 25954010
- CENP-C works as an important factor for centromeric M18BP1 recruitment PMID: 22540025
- Direct binding of Cenp-C to the Mis12 complex joins the inner and outer kinetochore. PMID: 21353556
- CENP-C may target the centromere by establishing multiple contacts with both the DNA and protein constituents of the kinetochore PMID: 12490152
- CENPC target sites that can be sumoylated by SUMO-2 were shown to be equally susceptible to SUMO-1 attachments which include specific sites on SUMO-2 itself, Ubc9, and the recombinant CENP-C fragments PMID: 15272016
- a functional interplay between the chromosomal passenger complex and CENP-C. PMID: 17287400
- Using protein truncation and in vitro mutagenesis, we have identified the nucleolar localization sequences on CENPC1,and evidence shows that CENPC1 is an RNA-associating protein that binds alpha-satellite RNA by an in vitro binding assay. PMID: 17623812
- CENP-C and CENP-H co-localize to the CENP-A chromatin domain. PMID: 17651496
- DNMT3B interacts with CENP-C to modulate DNA methylation and the histone code at centromere. PMID: 19482874
- C-terminal domain of CENP-C displays multiple and critical functions for mammalian centromere formation PMID: 19503796
顯示更多
收起更多
-
亞細胞定位:Nucleus. Chromosome, centromere, kinetochore. Chromosome, centromere.
-
蛋白家族:CENP-C/MIF2 family
-
數(shù)據(jù)庫鏈接:
Most popular with customers
-
-
YWHAB Recombinant Monoclonal Antibody
Applications: ELISA, WB, IHC, IF, FC
Species Reactivity: Human, Mouse, Rat
-
-
-
-
-
-